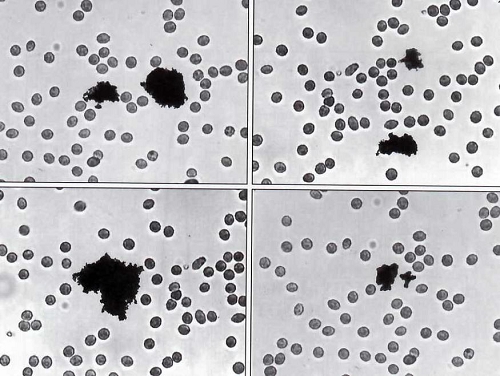

Miracle eucharistique
VIIe siècle
Le miracle eucharistique de Lanciano
_________________________

_____________
Histoire
 Le miracle eucharistique de Lanciano est le plus ancien de tous ceux où les saintes Espèces furent changées en chair et en sang : il remonte, en effet, au VIIIe siècle. Mais par les analyses qui furent faites de ses « reliques » en 1970-71 et en 1973-74, ce prodige est redevenu étonnamment actuel et jamais on n'a vu une simple tradition, qui remonte à douze siècles, confirmée par la science avec une telle netteté.
Le miracle eucharistique de Lanciano est le plus ancien de tous ceux où les saintes Espèces furent changées en chair et en sang : il remonte, en effet, au VIIIe siècle. Mais par les analyses qui furent faites de ses « reliques » en 1970-71 et en 1973-74, ce prodige est redevenu étonnamment actuel et jamais on n'a vu une simple tradition, qui remonte à douze siècles, confirmée par la science avec une telle netteté.
Lanciano (Le nom ancien de Lanciano fut Anxa, Anxanum ou Ansanum. Ce dernier terme se transforma en Lanzanum, mot qui évoque celui de « lancia », la lance : cette arme figurait dans les armes angevines de la cité, par allusion à sa participation aux croisades et peut-être aussi parce que, selon la tradition, le soldat Longin était originaire de ce pays), petite cité des Abruzzes, est située à 4 km environ de l'autoroute Pescara-Bari qui longe l'Adriatique, un peu au sud de Chieti. Dans une petite église dédiée à saint Legonziano - (que l'on a voulu identifier à saint Longin, le soldat qui transperça le côté et le Coeur du Christ mort en croix) - un moine basilien, qui célébrait la messe en rite latin (Il utilisait en tout cas, comme les latins, une hostie de forme ronde et non point comme les grecs une hostie carrée de pain fermenté), après la consécration se mit à douter de la présence réelle du Christ sous les saintes Espèces. C'est alors que, sous les yeux de ce prêtre, l'hostie se changea en un morceau de chair et le vin consacré en du sang réel qui se coagula en cinq caillots irréguliers de formes et de grosseurs différentes.
Le miracle fut consigné sur un très ancien parchemin, mais celui-ci, dans la première moitié du XVe siècle, fut volé aux franciscains par deux moines basiliens. On ne possède aujourd'hui sur le miracle que des textes remontant aux XVIe et XVIIe siècles, c'est-à-dire au moins huit cents ans après l'événement. Mais une tradition constante garda le souvenir du prodige et surtout les reliques en furent conservées.
Le culte des reliques eucharistiques
 Les moins basiliens qui desservaient l'église de San Legonziano quittèrent Lanciano au XIIe siècle ; le couvent passa ensuite aux bénédictins, puis, en 1253, aux franciscains conventuels qui, en 1258, reconstruisirent l'église et la dédièrent à saint François. Ces religieux durent à leur tour quitter les lieux en 1809, lorsque Napoléon Ier supprima les ordres religieux. Ils ne réoccupèrent leur antique couvent qu'en juin 1953.
Les moins basiliens qui desservaient l'église de San Legonziano quittèrent Lanciano au XIIe siècle ; le couvent passa ensuite aux bénédictins, puis, en 1253, aux franciscains conventuels qui, en 1258, reconstruisirent l'église et la dédièrent à saint François. Ces religieux durent à leur tour quitter les lieux en 1809, lorsque Napoléon Ier supprima les ordres religieux. Ils ne réoccupèrent leur antique couvent qu'en juin 1953.
Quant aux reliques, enfermées dans un reliquaire d'ivoire, elles furent conservées d'abord en l'église Saint-Legontien, puis en celle de Saint-François. Au moment des incursions turques dans les Abruzzes, un frère mineur, du nom de Jean-Antoine de Mastro Renzo, voulut les sauver et, le 1er août 1566, partit en les emportant. Mais après avoir marché toute la nuit, il se retrouva le lendemain matin aux portes mêmes de Lanciano. Il comprit alors que lui et ses compagnons devaient y demeurer pour garder les reliques. Celles-ci, une fois passé le danger, furent placées sur un autel digne d'elles, à droite de l'unique nef de l'église conventuelle. Elles étaient encloses en un vase de cristal, déposé lui-même dans une armoire de bois fermée par quatre clés. En 1920, elles furent placées en arrière du nouvel autel majeur. Depuis 1923 la « chair » est exposée dans le soleil d'un ostensoir, tandis que les caillots de sang desséché sont contenus dans une sorte de calice de cristal dans le pied de cet ostensoir.
Avant celle de 1970, plusieurs reconnaissances de ces reliques avaient eu lieu, en 1574, 1637, 1770 et 1886. Lors de celle de 1574, l'archevêque Rodriguez constata que le poids total des cinq caillots de sang équivalait au poids de chacun d'eux. Ce fait extraordinaire ne fut pas vérifié ultérieurement. Le poids actuel de l'ensemble des caillots est de 16,505 g et celui de chacun d'eux est de 8 g, 2,45 g, 2,85 g, 2,05 g, 1,15 g ; il faut y ajouter 5 mg de poussière de sang. Divers documents attestent à partir du XVIe siècle, la vénération rendue aux « reliques » et l'habitude que l'on avait de les porter en procession lors des nécessités graves et urgentes.
L'examen scientifique

Premier examen
En novembre 1970, sur les instances de l'archevêque de Lanciano, Mgr Perantoni, et du ministre provincial des conventuels des Abruzzes, et avec l'autorisation de Rome, les franciscains de Lanciano décidèrent de faire procéder à un examen scientifique de ces « reliques » qui dataient de près de douze siècles. L'entreprise était osée assurément mais ni la foi catholique (qui ici n'était pas en jeu), ni une tradition historique certaine, n'ont rien à redouter de la science, chacune de ces disciplines restant néanmoins dans son domaine propre.
L'entreprise fut confiée au docteur Odoardo Linoli, chef de service à l'hôpital d'Arezzo et professeur d'anatomie, d'histologie, de chimie et de microscopie clinique, aidé du professeur Ruggero Bertelli de l'Université de Sienne. Le Dr Linoli effectua des prélèvements sur les saintes reliques le 18 novembre 1970, puis il fit les analyses en laboratoire. Le 4 mars 1971, lé professeur produisit un compte-rendu détaillé des diverses études qu'il avait effectuées. Nous en tirons les conclusions essentielles :
La « chair miraculeuse » est vraiment de la chair, constituée de tissu musculaire strié du myocarde.
Le « sang miraculeux » est du sang véritable : l'analyse chromatographique le démontre avec une certitude absolue et indiscutable.
L'étude immunologique manifeste que la chair et le sang sont bien de nature humaine et l'épreuve immunohématologique permet d'affirmer en toute objectivité et certitude que l'un et l'autre appartiennent au même groupe sanguin AB. Cette identité du groupe sanguin peut indiquer l'appartenance de la chair et du sang à la même personne, la possibilité demeurant néanmoins d'une appartenance à deux individus différents de même groupe sanguin.
Les protéines contenues dans le sang sont normalement réparties, dans un pourcentage identique à celui du schéma séro-protéique du sang frais normal.
Aucune section histologique n'a révélé la trace d'infiltrations de sels ou de substances conservatrices utilisées dans l'antiquité aux fins de momification. Certes, la conservation les protéines et des minéraux observée dans la chair et le sang de Lanciano n'est ni impossible, ni exceptionnelle : des analyses répétées ont permis de trouver des protéines dans des momies égyptiennes de 4 et 5 000 ans. Mais il convient de souligner que le cas d'un corps momifié grâce aux procédés connus est bien différent de celui d'un fragment de myocarde laissé à l'état naturel pendant des siècles, exposé à l'action d'agents physiques atmosphériques et biochimiques.
Le professeur Linoli écarte, de même, l'hypothèse d'un faux opéré dans les siècles passés : « En effet, dit-il, à supposer que l'on ait prélevé le cceur d'un cadavre, j'affirme que seule une main experte en dissection anatomique aurait pu obtenir une "tranche" uniforme d'un viscère creux (comme on peut encore l'entrevoir sur la "chair") et tangentielle à la surface de ce viscère, comme donne à penser le cours prévalamment longitudinal des faisceaux de fibres musculaires, visible en plusieurs points dans les préparations histologiques. De plus, si le sang avait été prélevé sur un cadavre, il se serait rapidement altéré, par déliquescence ou putréfaction. »

Nouvel examen scientifique
La relation du professeur Linoli fut publiée dans Quaderni Sclavo in Diagnostica, 1971, fasc. 3 (Grafiche Meini, Siena) et suscita un grand intérêt dans le monde scientifique. Aussi en 1973, le Conseil supérieur de l'organisation mondiale de la Santé, O.M.S./O.N.U., nomma une commission scientifique pour vérifier, par des expériences de contrôle, les conclusions du clinicien italien. Les travaux durèrent quinze mois pour un total de cinq cents examens. Les recherches furent les mêmes que celles qu'avait effectuées le Dr Linoli, avec d'autres complémentaires. La conclusion de toutes les réactions et de toutes les recherches confirmèrent ce qui avait été déclaré et publié en Italie. De façon précise, il fut affirmé que les fragments prélevés à Lanciano ne pouvaient être assimilés à des tissus momifiés. Leur conservation depuis près de douze siècles en des reliquaires de verre et en l'absence de substances conservatrices, antiseptiques, antifermentatives et momisubstances conservatrices, antiseptiques, antifermentatives et momifiantes, n'est pas scientifiquement explicable : en effet, les vases qui les renferment n'empêchent pas l'accès de l'air et de la lumière, ni l'entrée de parasites d'ordre végétal ou animal, véhiculés d'habitude par l'air atmosphérique. Quant à la nature du fragment de chair, la commission déclare sans hésitation qu'il s'agit d'un tissu vivant en tant qu'il répond rapidement à toutes les réactions cliniques propres aux organismes vivants.
Un tel diagnostic, on le constate, confirme pleinement les conclusions du professeur Linoli. Et il n'est pas moins surprenant de voir comment un miracle italien du haut moyen âge a intéressé à ce point l'O.M.S. et les Nations Unies ! Mais - et c'est une autre surprise - l'extrait-résumé des travaux scientifiques de la commission médicale de l'O.M.S./O.N.U., publié en décembre 1976 à New York et à Genève, déclare en sa conclusion que la science, consciente de ses limites, s'arrête devant l'impossibilité de donner une explication. Le dernier paragraphe n'est certes pas une déclaration de foi religieuse, mais c'est, du moins, l'apologie de l'humilité que doit posséder celui qui s'adonne à la recherche scientifique. Le savant, à un certain point de ses investigations, doit se souvenir qu'il n'est rien de plus qu'un homme sur la planète terre.
Deux remarques d'ordre spirituel
La chair et le sang miraculeux de Lanciano sont donc tels que si on les avait prélevés le jour même sur un vivant. Or, dans l'Eucharistie, c'est bien un vivant qui se donne à nous, jésus, le ressuscité de Pâques, qui avait déclaré : « Je suis le Pain vivant descendu du ciel et ce que je donne, c'est ma chair pour la vie du monde. » Lorsque nous communions, nous mangeons vraiment, de manière sacramentelle, une chair réelle, animée et glorieuse, et nous buvons le sang vivant de l'Homme-Dieu qui, sorti du tombeau, ne peut plus mourir.
D'autre part, la chair de Lanciano est un tissu du coeur. Or, celui-ci symbolise, plus que toute autre partie du Corps du Christ, l'amour que ce dernier nous témoigne. Certes, en communiant, c'est le Corps tout entier du Seigneur que nous recevons sous les saintes Espèces, mais c'est d'abord son Coeur qui se donne à nous dans le « sacrement de son amour ». Se réalise alors pour chacun de nous la parole de saint Jean : « Jésus, ayant aimé les siens qui étaient dans le monde, les aima jusqu'à la fin », jusqu'à sa mort sur la croix assurément, mais surtout jusqu'à se donner à eux en nourriture, leur communiquant ainsi le bénéfice de sa mort rédemptrice et de sa vie glorieuse.
Le miracle de Lanciano, attesté historiquement par une longue tradition, authentiqué par la science elle-même, a, plus encore, une portée spirituelle et mystique : il nous fait saisir que le Christ est bien vivant et que son Coeur passionnément nous aime. Quel adjuvant par conséquent pour notre foi qu'un tel prodige ! Et comme il nous porte à rendre grâces à Celui qui nous a aimés le premier et jusqu'à nous donner sa chair et son sang en nourriture et en breuvage !
Source : Abbé Jean Ladame, "Prodiges Eucharistiques", Edts "Familles et Eucharistie.
_________________________
L'Evénement
Le Miracle Eucharistique de Lanciano s'est produit vers l'an sept cents. Il découle des circonstances et concomitances historiques dues à la persécution en Orient de la part de l'Empereur Léon III, l'Isaurique, lequel commença une persécution féroce contre l'Eglise et le culte des images sacrées (iconoclaste). En concomitance à la "lutte iconoclaste" dans l'Eglise orientale, de nombreux moines grecs se réfugièrent en Italie, parmi ceux-ci figurent les moines basiliens, disciples de Saint Basile (329-379) Evêque de Césarée de Cappadoce (dans l'actuelle Turquie Orientale). Quelques communautés de ces moines trouvèrent asile à Lanciano.
Un jour un moine pendant qu'il célébrait la Sainte Messe fut assailli du doute quant à la présence réelle de Jésus dans la Sainte Eucharistie. Prononcées les paroles de la consécration sur le pain et sur le vin, à l'improviste, devant ses yeux il vit le pain transformé en Chair et le vin en Sang.
La tradition, moins attentive que nous aujourd'hui aux particularités des vicissitudes de la vie, ne nous a pas consigné les données d'état-civil du moine-prêtre, dans les mains duquel s'est vérifié l'extraordinaire et inattendu changement. Nous savons que c'était un moine de rite oriental, grec, appartenant à la grande famille spirituelle des basiliens. Un document de 1631 référant le Prodige avec abondance de détails, nous aide à entrer dans le monde intérieur du protagoniste anonyme, le dépeignant comme "pas très ferme dans la foi, lettré des sciences du monde mais ignorant en celles de Dieu; allait doutant de jour en jour si dans l'Hostie consacrée fut le vrai Corps du Christ et dans le vin fut le vrai Sang".
Donc un homme tourmenté par le doute, désorienté par les différents courants d'opinion, de même dans le domaine de la foi, lacéré par les inquiétudes quotidiennes.
Quelle fut sa réaction devant l'inattendue mutation qui impliquait les espèces sacramentelles? Se reportant au document cité, nous lisons: "Attéré et confus par un aussi grand et merveilleux miracle, il resta un long moment comme transporté dans une extase divine; finalement, cédant la peur à l'allégresse spirituelle, qui lui emplissait l'âme avec un visage joyeux baigné de larmes, se tournant vers les personnes présentes, il leur dit ainsi: 'Ô heureux fidèles auxquels le Dieu Béni, pour confondre mon incrédulité a voulu se révéler dans ce très saint Sacrement et se rendre visible à vos yeux. Venez, frères, et admirez Notre Dieu qui s'est fait proche de nous'". C'est le sentiment commun qui nous accompagne à chaque expérience de Dieu et de sa mystérieuse influence sur les enfants des hommes. Le pain et le vin, investis de la force créatrice et sanctificatrice de la Parole, se sont changés subitement, totalement et visiblement en Chair et en Sang.
La datation
Nous n'avons aucun élément à disposition qui nous permet de fixer le jour, le mois et l'année où s'est produit l'Evénement. Le témoignage historique tardif et la tradition orale unanime déterminent le Fait se rapportant au VIIIe siècle, sans précisions ultérieures.
L'histoire du siècle en question nous aide dans une certaine mesure. Nous savons exactement qu'en Orient, sous l'Empereur Léon III, une virulente lutte iconoclaste se déclencha contre le culte des images sacrées, culte retenu légitime et théologiquement inattaquable par l'Eglise romaine. Un fait douloureux daté de l'an 725 qui détermina une augmentation du flux migratoire des moines grecs en Italie, dont la petite communauté aboutie à Lanciano.
A la lumière de ce cadre général de références, nous pouvons retenir raisonnablement fondé, avec une bonne approximation, que le Miracle se soit vérifié entre les années 730-750 de l'ère chrétienne.
La confirmation documentaire
Faisant abstraction des résultats positifs de la recherche scientifique, celui qui désire connaître l'histoire et le culte des Reliques du Miracle Eucharistique dispose d'autres éléments informatifs disséminés dans le temps; toutefois, le matériel de documentation insuffisant ne devrait surprendre personne quant à un événement qui remonte au VIIe siècle. Cependant, non seulement par la fréquentation d'archives mais aussi d'autres sources, on constate la disparition inconsidérée de documents et la destruction inconsciente de parchemins survenue à Lanciano et ailleurs. En général, cela peut s'attribuer soit aux conditions politiques et sociales précaires vérifiées sur large échelle, surtout aux alentours de l'an mille, soit à d'autres causes : à la rareté des moyens de communication écrite (presque tout était confié à la tradition orale ou à l'oeuvre inlassable de quelques copistes) s'ajoutent les incendies et les pillages dévorateurs, les guerres fréquentes et les immanquables tremblements de terre, la négligence humaine et l'utilisation indifférente des parchemins comme couvertures d'ouvrages, comme lampions pour l'illumination à pétrole ou comme vulgaire papier pour envelopper des marchandises variées.
Le premier document écrit date de 1631 et se réfère dans les plus petits détails à ce qui est arrivé au moine. Dans le presbytère du sanctuaire, sur le côté droit de la Chapelle Valsecca, on peut lire l'épigraphe datée 1636, où est narré en synthèse l'Evénement.
Nous pouvons aussi ajouter dans cette section les diverses Reconnaissances sur le Miracle. Celles-ci sont des vérifications historiques et juridiques pour affirmer au cours des siècles l'authenticité du Miracle de la part de l'Autorité ecclésiastique.
La première Reconnaissance eut lieu en 1574 par l'Archevêque Gaspare Rodriguez, lequel constata que le poids total des cinq caillots de sang équivalait au poids de chacun de ceux-ci. Ce fait extraordinaire ne fut pas vérifié ultérieurement. Le poids global actuel des caillots est de 16,505 g., celui de chacun de ceux-ci est de 8 g.; de 2,45 g.; de 2,85 g.; de 2,05 g. et de 1,15 g. Il faut ajouter 5 mg. de poudre de sang. A partir du XVIe siècle, divers documents attestent la vénération rendue aux "reliques" et la coutume qu'on avait de les porter en procession dans les moments urgents et de graves nécessités.
D'autres Reconnaissances eurent lieu en 1637, 1770, 1866, 1970.
La Localisation
Nous sommes dans le "beau Pays" l'Italie, dans la région des Abruzzes, province de Chieti, dans la ville de Lanciano. A deux pas de la très centrée place Plebiscito, au coeur du centre historique, une petite église dédiée à San Legonziano était ouverte au public, confiée par le sénat et par le peuple de Lanciano à un modeste groupe de moines basiliens, parvenus comme réfugiés dans le chef-lieu frenan. Le Miracle Eucharistique se vérifia dans ladite église, dans les mains de l'un de ces moines orientaux.
De récentes recherches archéologiques confirment abondamment la présence de byzantins dans la zone à l'époque où nous parlons. En fait, ont été retrouvées des pièces de céramique décorées à bandes, typiques de l'ère byzantine. L'archéologue Andrea Staffa soutient: "Exactement au-dessous de l'autel actuel du Sanctuaire (de l'église de san Francesco) a été découverte une salle en maçonnerie de pierres d'équarrissage quadrangulaires, qui remonte certainement à l'installation originaire du lieu de culte".
Les Reliques du Miracle furent conservées dans la petite église originaire jusqu'en 1258, passant successivement des mains des basiliens à celles des bénédictins (env. 1074) et après la parenthèse archipresbytérale (1229-1252) dans les mains des franciscains.
La proximité du monastère florissant de San Giovanni in Venere (à la périphérie de Fossacesia), aujourd'hui confié aux Pères Passionnistes, en coïncidence avec le déclin de la présence byzantine, favorisa l'installation des bénédictins dans l'église de San Legonziano et ceci entre les années 1047 et 1076.
Le monastère bénédictin commença à vivre et à connaître son inextinguible courbe descendante à partir de 1225, à la suite de facteurs internes et aux comportements anti-impériaux, qui décrétèrent son expulsion de Lanciano en 1229.
L'église du Miracle fut alors confiée au clergé local, en la personne de l'archiprêtre, jusqu'à la venue des franciscains le 3 avril 1252. En 1258 les frères franciscains reconstruirent l'église et la dédièrent à San Francesco. En 1809, lorsque Napoléon Ier supprima les ordres religieux, ils durent à leur tour quitter ce lieu. C'est seulement en juin 1953 qu'ils retrouvèrent leur ancien couvent.
Les reliques, enfermées dans un reliquaire d'ivoire, furent conservées premièrement dans l'église de San Legonziano et ensuite dans celle de San Francesco. Au temps des incursions des turcs dans les Abruzzes, un frère mineur, nommé Giovanni Antonio di Mastro Renzo, voulut les sauver et le 1er Août 1566 partit en les emportant avec lui. Après avoir marché toute la nuit, le lendemain matin il se retrouva encore aux portes de Lanciano.
Il comprit alors qu'il devait rester avec ses compagnons pour conserver les reliques. Celles-ci, une fois le danger passé, furent déposées sur un autel digne d'elles, sur le côté droit de l'unique nef de l'église conventuelle.
Elles furent enfermées dans un vase de cristal, celui-ci déposé dans une armoire en bois, fermé avec quatre clés. En 1920, les reliques furent déposées derrière le nouvel autel majeur. Depuis 1923, la "chair" est exposée dans le soleil d'un ostensoir, alors que les caillots de sang desséchés, sont contenus dans un calice de cristal au pied de cet ostensoir.
L'examen scientifique
En novembre 1970, sur les instances de l'archevêque de Lanciano, Monseigneur Perantoni et du ministre provincial des Conventuels des Abruzzes et avec l'autorisation de Rome, les Franciscains de Lanciano décidèrent de soumettre à un examen scientifique ces "reliques" qui dataient d'environ 12 siècles. C'était certainement un défi : mais ni la foi catholique (qui n'entrait pas en jeu), ni la tradition historique n'avaient certainement rien à craindre de la science car chacune restait dans son propre domaine.
La tâche fut confiée au docteur Edoardo Linoli, chef de service à l'hôpital d'Arezzo et professeur d'anatomie, d'histologie, de chimie et de microscopie clinique, assisté par le prof. Ruggero Bertelli de l'Université de Sienne. Le 18 novembre 1970, le docteur Linoli effectua des prélèvements sur les reliques sacrées et procéda aux analyses en laboratoire.
Le 4 mars 1971, le professeur présenta un compte-rendu détaillé des diverses études effectuées. En voici les conclusions essentielles:
1. La "chair miraculeuse" est vraiment chair constituée du tissu musculaire strié du myocarde.
2. Le "sang miraculeux" est vrai sang: les analyses chromatographiques le démontrent avec certitude absolue et indiscutable.
3. L'étude immunologique démontre que la chair et le sang sont vraiment de nature humaine et la preuve immuno-hématologique permet d'affirmer avec toute objectivité et certitude que tous deux appartiennent au même groupe sanguin AB. Cette identité du groupe sanguin peut indiquer l'appartenance de la chair et du sang à la même personne, avec toutefois la possibilité de l'appartenance à deux individus différents du même groupe sanguin.
4. Les protéines contenues dans le sang sont normalement réparties dans un pourcentage identique à celui du schéma sérum-protéique du sang frais normal.
5. Aucune section histologique n'a révélé des traces d'infiltrations de sels ou de substances conservatrices utilisées dans l'antiquité à des fins de momification. Naturellement, la conservation de protéines et de minéraux observés dans la chair et dans le sang de Lanciano n'est pas impossible ni exceptionnelle : les analyses répétées ont permis de trouver des protéines dans les momies égyptiennes de 4 et de 5000 ans. Mais il est opportun de souligner que le cas d'un corps momifié selon les procédés connus est très différent de celui d'un fragment du myocarde laissé à l'état naturel pendant des siècles, exposé aux agents physiques atmosphériques et biochimiques.
Le prof. Linoli écarte même l'hypothèse d'une imposture commise dans les siècles passés. "En fait, dit-il, supposant qu'ont ait prélevé le coeur d'un cadavre, j'affirme que seulement une main experte en dissection anatomique aurait pu obtenir une "coupe" uniforme d'une viscère creuse (comme on peut encore l'entrevoir sur la "chair") et tangentielle à la superficie de cette viscère, comme le démontre le cours longitudinal, de façon prédominante, des bandes des fibres musculaires, visibles en plusieurs points dans les préparations histologiques. En outre, si le sang avait été prélevé sur un cadavre, il se serait rapidement altéré par déliquescence ou putréfaction."
Nouvel examen scienfique
Le rapport du prof. Linoli fut publié dans "Quaderni Sclavo in Diagnostica", 1971, fasc. 3 (Grafiche Meini, Siena) et suscita un vif intérêt dans le monde scientifique. Aussi en 1973, le Conseil Supérieur de l'Organisation mondiale de la Santé O.M.S./O.N.U. nomma une commission scientifique pour vérifier, selon des expériences de contrôle, les conclusions du médecin italien. Les travaux durèrent 15 mois avec un total de 500 examens. Les recherches furent les mêmes que celles effectuées par le prof. Linoli, avec d'autres compléments. La conclusion de toutes les réactions et de toutes les recherches confirmèrent ce qui avait déjà été déclaré et publié en Italie.
De manière précise, il fut affirmé que les fragments prélevés à Lanciano ne pouvaient pas être assimilés à des tissus momifiés. Leur conservation après presque douze siècles, dans des reliquaires de verre et en l'absence de substances conservatives, antiseptiques, antifermentatives et momificantes, n'est pas scientifiquement expliquable : en fait les vases qui renferment ces reliques n'empêchent pas l'accès de l'air et de la lumière ni l'entrée de parasites d'ordre végétal ou animal, véhicules ordinaires de l'air atmosphérique. Quant à la nature du fragment de chair, la commission déclare sans hésitation qu'il s'agit d'un tissu vivant car il répond rapidement à toutes les réactions cliniques propres aux êtres vivants.
Ce verdict confirme donc pleinement les conclusions du prof. Linoli. Il n'est pas moins surprenant de constater qu'un miracle italien du haut Moyen Âge ait intéressé à ce point l'OMS et les Nations Unies! Mais voilà une autre surprise, l'extrait du compte-rendu des travaux scientifiques de la Commission Médicale de l'OMS et de l'ONU, publié en décembre 1976 à New-York et à Genève, déclare dans sa conclusion que la science, consciente de ses limites, se rend devant l'impossibilité de donner une explication. Le dernier paragraphe n'est certainement pas une déclaration de foi religieuse mais c'est au moins l'apologie de l'humilité que doit posséder celui qui se dévoue à la recherche scientifique. Le scientifique, à un certain moment de ses investigations, doit se rappeler qu'il n'est rien d'autre qu'un homme sur la planète terre.
Quelques illustrations afin de mieux expliquer les examens scientifiques exécutés

Fig. 1 - (Eosina x 200). Aspect histologique général d'un échantillon de la Chair, avec fibres récoltées en faisceaux de façon longitudinale, comme dans les couches superficielles externes du coeur.

Fig. 2 - le Coeur du Miracle de lanciano (Mallory x 250). Une artère et, très près, une ramification du nerf vagal.

Fig. 3 - Le Coeur du Miracle de Lanciano (Mallory x 400). On peut voir l'aspect classique "rêche" de l'endocarde; la structure syncytiale du tissu du myocarde.
Fig. 4 - (x 80). Au-dessus : Test d'hémagglutination effectué sur un échantillon de Sang de Lanciano : à gauche sérum anti-A; à droite, sérum anti-B. Au-dessous : Test d'hémagglutination effectué sur un échantillon de la Chair de Lanciano : à gauche, sérum anti-A; à droite, sérum anti-B. Il apparaît ainsi que la Chair et le Sang de Lanciano appartiennent au groupe sanguin AB.

Fig. 5 - Tracé d'électrophorèse des protéines du Sang.
_________________________
